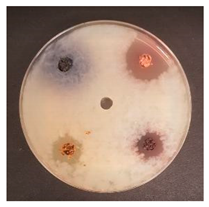
Foods 09 01620 i002 Foods 09 01620 i002
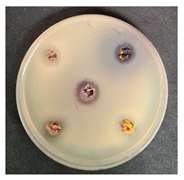
Foods 09 01620 i008 Foods 09 01620 i008

Abstract
This study aims to develop nutraceutical beverages containing food processing by-products in their formulation, and determine the opinion of consumers. This is done by testing whether they know that the main ingredients of the product are by-products, performing an overall acceptability test of the developed beverages, and evaluating the emotions induced by the newly developed beverages for consumers. The main ingredients used for the preparation of added-value beverages were fermented milk permeate (containing galactooligosaccharides), extruded and fermented wheat bran (WB) (containing ≥6.0 log10 CFU g−1 viable antimicrobial properties showing lactic acid bacteria (LAB) strains), and different fruit/berry by-products (FBB) (as a source of compounds showing antioxidant properties). The definition of the quantities of bioactive ingredients was based on the overall acceptability of the prepared beverages, as well as on emotions induced in consumers by the tested beverages. Functional properties of the developed beverages were proofed by the evaluation of their antimicrobial and antioxidant properties, as well as viable LAB count during storage. Desirable changes in extruded and fermented WB were obtained: Fermentation reduced sugar concentration and pH in samples with predominant lactic acid isomer L(+). In addition, the viable LAB count in the substrate was higher than 6.0 log10 CFU g−1, and no enterobacteria remained. By comparing the overall acceptability of the beverages enriched with WB, the highest overall acceptability was shown for the samples prepared with 10 g of the extruded and fermented WB (7.9 points). FBB showed desirable antimicrobial activity: Shepherd inhibited—2, sea buckthorn—3, blueberries—5, and raspberries—7 pathogens from the 10 tested. Comparing different beverage groups prepared with different types of FBB, in most cases (except sea buckthorn), by increasing FBB content the beverages overall acceptability was increased, and the highest score (on average, 9.5 points) was obtained for the samples prepared with 5.0 and 7.5 g of blueberries FBB. Moreover, a very strong positive correlation (r = 0.8525) was found between overall acceptability and emotion “happy” induced in consumers by the prepared beverages enriched with extruded and fermented WB and FBB. By comparing the samples prepared with the addition of WB with samples prepared with WB and FBB, it was observed that most FBB increased total phenolic compounds (TPC) content (on average, by 9.0%), except in the case of samples prepared with sea buckthorn. A very high positive correlation (r = 0.9919) was established between TPC and antioxidant activity. Finally, it can be stated that the newly developed nutraceutical beverages were acceptable for consumers, induced positive emotions, and possessed desirable antimicrobial and antioxidant properties, while being prepared in a sustainable and environmentally friendly manner.
1. Introduction
According to future prognosis, the global population will increase to 8 billion by 2030 and more than nine billion by 2050, and such population growth will lead to the need for high-quality foods to be assured [1]. However, nowadays, a significant part of the world’s population is suffering from malnutrition [1]. To ensure enough balanced food is available, the food industry must move to become a sustainable industry, in which by-products are very effectively recovered as high-value ingredients and (or) products. However, the food system is highly complex and is driven by many economic, cultural and environmental factors [1]. It should be mentioned that until now, many high-value food industry by-products are used as a low-value feedstock for livestock feeding. At the same time, many people are suffering from biologically active compounds (antioxidants, dietary fibre, etc.) deficiency [1]. As is the case with many food processing industries, by-product recovery can reduce the quantity of wastes that require treatment; however, new technologies and new product formulations should be developed. From another point of view, knowing that the main ingredients of the product are by-products, will the consumer choose it? For this reason, in our study, in addition to the overall acceptability standard test, evaluation of the emotions induced by the newly developed beverages for consumers were measured. Emotion is usually defined as a rapid reaction to a stimulus, which could be a food or drink [2]. The application of emotions evaluation has grown in the last years because it can be used for a prognosis about the emotions induced for consumers by the different food, as well as a choice of food. The emotions induced by food for consumers can be linked to health-related problems [3], and also, can be adapted for commercial product development, to ensure their popularity in the market.
The highest quantity of food-processing by-products is generated by fruit and vegetable, dairy, meat, poultry, olive oil, fermentation, and seafood industries [4]. For this reason, for the development of added-value beverages in this study, milk permeates, wheat bran, and fruit/berries by-products were chosen.
Milk permeate (MP) is a dairy industry by-product obtained during the milk protein concentrate production. The MP, containing a high concentration of lactose, can be used as a stock for galactooligosaccharides (GOS) production [5]. Our previous studies showed that MP fermentation with selected lactic acid bacteria (LAB) strains could lead to additional value formation, by lactose converting to GOS [5]. GOS are desirable compounds in food because consumption of prebiotics is a useful strategy in order to prevent many diseases, and GOS, as a nutraceutical compound, can lead to protective biological functions, e.g., antitumour [6].
Another food industry sectors that generate high quantities of by-products is the wheat processing industry [7,8,9,10,11]. Wheat is the most valuable crop in the world; however, wheat generates very large amounts of by-products (approximate 15% of wheat is not used efficiently), but could be potentially used for the production of value-added products. However, the addition of WB to food formulations usually induces adverse effects on sensory properties of the final product [12]. Extrusion is proposed to increase the acceptability of WB by changing its properties. Extrusion is a combination of thermal and mechanical treatments where the substrate is subjected to high temperature and shear forces for a short time. This process is used to texturise food materials and can have a positive influence on a functional value of WB, e.g., by decreasing antinutritional factors [13,14,15,16]. Moreover, as a high-temperature process, extrusion can lead to reduced microbial contamination, and during the Maillard reaction, the aroma changes to be more acceptable for consumers. Therefore, this process could be used for WB pre-treatment to improve it as a food ingredient, improve sensory properties, as well as to reduce microbial contamination. In addition, fermentation with selected LAB strains can lead to extruded WB having additional value, for example, by providing antimicrobial properties. For this reason, we hypothesise that extruded and fermented WB can be a useful ingredient for additional value beverages development.
Another industry that generates large amounts of by-products is fruit/berries industry. In this study, Sambucus nigra L., Rubus idaeus L., Hippophae rhamnoides L., and Vaccinium myrtillus L. by-products were used for the development of additional value beverages. Sambucus nigra L., known as elderberry, is a very popular species of the Adoxaceae family [17]. Elderberry is a very popular ingredient in many foods and beverage formulations: wine, juice, tea, liqueur, muffins, pancakes, jams and jellies, waffles, batter, etc. [18]. Elderberries are popular in folk and professional medicine, because of high quantities of bioactive compounds possessing desirable characteristics for health improvement [19,20,21,22,23]. Several papers have been published about their antioxidant activities [21,24,25,26].
Red raspberries (Rubus idaeus L.) are very popular worldwide and consumed as fresh or processed into a variety of products: confitures, juice, jams, etc. [27]. Due to their phenolic compounds and vitamin C, red raspberries possesses antitumoural, antibacterial, and antioxidant activities [28,29,30,31,32,33,34].
Sea buckthorn (Hippophae rhamnoides L.) is an ecologically and economically important plant [35]. Sea buckthorn berries contain a high amount of various hydrophilic and lipophilic compounds, carotenoids, polyphenols, organic, amino and fatty acids, minerals, etc. [36,37,38,39,40]. Sea buckthorn berries are used for high added-value juice and oil production [41]; therefore, the remaining pulp can be used for added-value products development. Blueberry (Vaccinium myrtillus L.) species are distributed all over the world [42]. These fruits are usually consumed in the fresh form, however, due to their short shelf life, they are used for jams, juices, wines, or liqueurs production [43]. These berries are conventionally used in medicine [44], because of their high content of phenolics and carotenoids, as well as vitamins. The European blueberry is an economically valuable wild berry, well-known for its richness of antioxidants (anthocyanins) [42,43]. Blueberries are used for various food and beverage preparation, including juice and wine, and these processes generate valuable by-products, which can be used for further added-value product development.
The aim of this study was to develop additional value beverages in a sustainable manner by using a formulation of food processing by-products. The main ingredients for additional value beverage preparation were fermented milk permeate (containing GOS), extruded and fermented wheat bran (WB) (containing ≥6.0 log10 CFU g−1 viable antimicrobial properties showing LAB), and different fruit/berry by-products (as a source of antioxidant properties showing compounds). The main selection of the quantities of bioactive ingredients was based on the prepared beverages ‘overall acceptability, as well as on emotions induced by the tested beverages for consumers. Functional properties of the developed beverages were proofed by the evaluation of their antimicrobial and antioxidant properties, as well as viable LAB count in the developed drinks during the storage.
2. Materials and Methods
The whole experiment scheme is shown in Figure 1.
Figure 1.
The experimental scheme.
2.1. Characteristics of Fermented Milk Permeate used for Beverages Preparation
Milk permeate (MP) was obtained from the Agricultural cooperative “Pienas LT”, Biruliskes, Lithuania. Our previous studies showed that the highest concentration of galactooligosaccharides (GOS) and the most effective antimicrobial properties of MP could be obtained when P. acidilactici LUHS29 strain was used for MP fermentation [5]. Characteristics of the fermented MP, used in this study for enriched beverages preparation are shown in Table 1 (acidity parameters, LAB count, GOS concentration, overall acceptability and emotions induced for consumers) and Table 2 (antimicrobial properties).
Table 1.
Parameters after 48 h of milk permeate fermented with LUHS29 strain.
Table 2.
The diameter of inhibition zones (mm) of the prepared beverages against pathogenic and opportunistic strains of milk permeate fermented with LUHS29 strain.
2.2. Wheat Bran, Used for Beverages Enrichment, by Using it for Pre-Treatment Extrusion and Fermentation Processes
Wheat bran was obtained from the SME “Ustukiu malunas” (Pasvalys, Lithuania). Wheat bran samples (WB) were extruded at 130 °C, speed of the screw—25 rpm and fermented with L. uvarum LUHS245 strain. The LUHS245 strain, before the experiment, was stored at −80 °C in a Microbank system (Pro-Lab Diagnostics, Birkenhead, Wirral, UK) and grown in de Man, Rogosa and Sharpe (MRS) broth (CM 0359, Oxoid, Basingstoke, Hampshire, UK) at 30 °C for 48 h prior to use.
The following parameters for WB were established: pH, total titratable acidity (TTA), L(+) and D(-) lactic acid bacteria concentration, LAB, mould/yeast (M/Y), total bacteria (TBC), and total enterobacteria (TEC) counts; sugars concentration (fructose, glucose, sucrose, maltose); amino acids and biogenic amines concentration. Non-extruded and non-fermented WB samples were used as control.
Wheat Bran Analysis Methods
The pH was measured using a pH electrode (PP-15; Sartorius, Goettingen, Germany). The total titratable acidity (TTA) was evaluated for a 10 g sample of sample mixed with 90 mL of water, and the results were expressed in mL of 0.1 mol L−1 NaOH solution required to achieve a pH value of 8.2. For L(+) and D(−) lactic acid isomers concentration evaluation, a specific Megazyme assay Kit (Megazyme Int., Bray, Ireland) was used. The determination of LAB, total bacteria (TBC), enterobacteria (TEC), and mould/yeast (M/Y) counts in samples was performed according to Bartkiene et al. [45].
To determine the sugar concentration, 2–3 g of sample was diluted with ~70 ml of distilled/deionised water, heated to 60 °C in a water bath for 15 min, clarified with 2.5 ml Carrez I (85 mM K4[Fe(CN)6] × 3H2O) and 2.5 ml Carrez II (250 mM ZnSO4 × 7H2O) solutions, and made up to 100 ml with distilled/deionised water. After 15 min, the samples were filtered through a filter paper and a 0.22 μm nylon syringe filter before analysis. A standard solution of a sugar’s mixture was prepared by dissolving 0.2 g each of fructose (Hamburg, Germany), glucose (Sigma-Aldrich, Hamburg Germany), sucrose (Sigma-Aldrich, Hamburg Germany) and maltose (Sigma-Aldrich, Hamburg, Germany) in 100 mL of distilled/deionised water. A 2 mg mL−1 standard solution of sugars mixture was prepared following dilution with distilled/deionised water. Chromatographic conditions were as follows: The eluent was a mixture of 75 parts by volume of acetonitrile and 25 parts by volume water, the flow rate was 1.2 mL/min, 20 μL was injected. The YMC-Pack Polyamine II 250 × 4.6 mm, 5 μm (YMC Co., Ltd., Tokyo, Japan) column was used. The column temperature was set at 28 °C. Detection was performed using an Evaporative Light Scattering Detector ELSDLTII (Shimadzu Corp., Kyoto, Japan).
Free amino acids (FAA) were extracted using 0.1 M HCl. The extracts were analysed by gas chromatography with flame ionisation detection after an ion-exchange solid-phase extraction and chloroformate derivatisation using EZ:faast technology (Phenomenex) as described by Bartkiene et al. [46].
The extraction and determination of biogenic amines (BA) in wheat samples followed the procedures developed by Ben-Gigirey et al. [47] with some modifications, as described by Bartkiene et al. [48].
2.3. Fruits/Berries By-Products used for Milk Permeate Beverages Preparation
Four different fruit/berry by-products types (Shepherd/Sambucus nigra, Raspberries/Rubus idaeus, Sea buckthorns/Hippophae rhamnoides, Blueberries/Vaccinium myrtillus) were obtained from the Institute of Horticulture, Lithuanian Research Centre for Agriculture and Forestry (Babtai, Kaunas distr., Lithuania) in 2020. These by-products were vacuum dried in a vacuum dryer XF020 (France-Etuves, Chelles, France) at 45 ± 2.0 °C and a pressure of 6 × 10−3 mPa. The antimicrobial and antifungal properties for the selected fruit/berry by-products were evaluated.
Antimicrobial Properties of the Fruit/Berry By-Products Evaluation
The antimicrobial activity of fruit/berry by-products was evaluated against a variety of pathogenic and opportunistic bacterial strains (Salmonella enterica Infantis LT 101, Staphylococcus aureus LT 102, E. coli (hemolytic) LT 103, Bacillus pseudomycoides LT 104, Aeromonas veronii LT 105, Cronobacter sakazakii LT 106, Hafnia alvei LT 107, Enterococcus durans LT 108, Kluyvera cryocrescens LT 109, Acinetobacter johnsonii LT 110). The pathogenic and opportunistic bacterial strains used were obtained from the Lithuanian University of Health Sciences’ (Kaunas, Lithuania) collection. The antimicrobial activity of the fruit/berry by-products was assessed by measuring the diameter of inhibition zones (DIZ, mm) in agarwell diffusion assays. Accordingly, a 0.5 McFarland unit density suspension of each pathogenic bacteria strain was inoculated onto the surface of cooled Mueller–Hinton agar (Oxoid, Basingstoke, UK) using sterile cotton swabs. Wells of 6 mm in diameter were punched in the agar and filled with the tested by-product. Before the experiment, the fruit/berry by-products were diluted with a sterile physiological solution (1 g of the by-product diluted with 2 mL of the physiological solution). The average DIZ was calculated from triplicate experiments.
2.4. Selection of the Optimal Quantities of Technologically Functionalised Wheat Bran for Milk Permeate Beverages Enrichment
The different quantities (2.5, 5.0, 7.5, and 10 g) of WB were added to the fermented MP samples (50 mL), and the most acceptable samples for the further enrichment with fruit/berry by-products were selected. In addition, emotions induced for consumers by the prepared beverages enriched with extruded and fermented WB were evaluated. Description of the overall acceptability and emotions induced for consumers by the prepared beverages are described below in Section 2.3.
Overall Acceptability and Emotions Induced for Consumers by the Prepared Beverage Enriched with Wheat Bran Beverages Evaluation
The overall acceptability of the beverages was established by 50 judges, according to International Standards Organisation method 8586-1 [49], using a 10-point scale ranging from 0 (“extremely dislike”) to 10 (“extremely like”). Similarly, the prepared beverages were tested by applying FaceReader 6.0 software (Noldus Information Technology, Wageningen, The Netherlands), scaling nine emotion patterns (neutral, happy, sad, angry, surprised, scared, disgusted, contempt, and valence) according to Bartkiene et al. [50]. In the obvious measurement experiment, subjects were asked to rate the beverage samples during and after consumption with an intentional facial expression, which was recorded and then characterised by FaceReader 6.0. The participants were asked to taste the whole presented sample at once, take 15 s to reflect on the taste impressions, then give a signal with a hand and visualise the taste experience of the sample with a facial expression best representing their liking of the sample. The whole procedure was filmed using high-resolution Microsoft LifeCam Studio webcam mounted on a laptop facing the participants, and Media Recorder (Noldus Information Technology, Wageningen, The Netherlands) software. Special care was taken to ensure good illumination of participant’s faces. The recordings, using a resolution of 1280 × 720 at 30 frames per second, were saved as AVI files and analysed frame by frame with FaceReader 6 software, scaling the nine basic emotion patterns (neutral, happy, sad, angry, surprised, scared, disgusted, contempt and valence) to 1 (maximum intensity of the fitted model). In addition, the FaceReader also analysed the valence, which indicates whether the person’s emotional status is positive or negative. ‘Happy’ is the only positive emotion, while ‘Sad’, ‘Angry’, ‘Scared’, and ‘Disgusted’ are considered to be negative emotions. ‘Surprised’ can be either positive or negative. The valence is calculated as the intensity of ‘Happy’ minus the intensity of the negative emotion with the highest intensity. Valence scores ranged from -1 to 1. For each sample, the section of intentional facial expression (from the exact point at which the subject had finished raising their hand to give the signal until the subject started lowering their hand again) was extracted and used for statistical analysis.
2.5. Selection of the Optimal Quantities of Fruits/Berries By-Products for Milk Permeate Beverages Enrichment
The different quantities (2.5, 5.0, 7.5, 10 g) of fruit/berry by-products (Shepherd/Sambucus nigra, Raspberries/Rubus idaeus, Sea buckthorns/Hippophae rhamnoides, Blueberries/Vaccinium myrtillus) were tested. In addition to the optimal quantity of WB, the optimal quantity of the tested fruit/berry by-products was selected. First of all, the optimal quality was selected by the evaluation of overall acceptability and emotions induced for consumers by the prepared enriched with WB and fruit/berry by-products beverages (methods described in Section 2.3.
After an optimal (according to overall acceptability and induced emotions) fruit/berry by-products content selection, the most acceptable samples were analysed further, by evaluating prepared enriched beverages antimicrobial properties, LAB count during the storage, colour coordinates, and acidity parameters. Description of the above-mentioned methods is given in.
Antimicrobial Activity of the Prepared Beverages Enriched with Wheat Bran and Fruits/Berries By-Products
Antimicrobial activity of the prepared beverages enriched with extruded and fermented wheat bran and fruit/berry against a variety of pathogenic and opportunistic bacterial strains (Salmonella enterica Infantis LT 101, Staphylococcus aureus LT 102, E. coli (hemolytic) LT 103, Bacillus pseudomycoides LT 104, Aeromonas veronii LT 105, Cronobacter sakazakii LT 106, Hafnia alvei LT 107, Enterococcus durans LT 108, Kluyvera cryocrescens LT 109, Acinetobacter johnsonii LT 110) was evaluated. The used pathogenic and opportunistic bacterial strains were attained from the Lithuanian University of Health Sciences (Kaunas, Lithuania) collection. Antimicrobial activity was assessed by measuring the diameters of inhibition zones (DIZ, mm) in agar well diffusion assays. For this purpose, 0.5 McFarland unit density suspension of each pathogenic bacteria strain was inoculated onto the surface of cooled Mueller–Hinton agar (Oxoid, UK) using sterile cotton swabs. Wells of 6 mm in diameter were punched in the agar and filled with 50 µL of the prepared beverages samples. The average DIZ was calculated from triplicate experiments.
Acidity parameters (pH and TTA) of the prepared beverages enriched with extruded and fermented wheat bran and fruit/berries were evaluated immediately after preparing the beverages. The pH value of beverages was measured and recorded using a pH electrode (PP—15, Sartorius, Goettingen, Germany). The total titratable acidity (TTA) was determined of a 10 mL sample homogenised with 90 mL distilled water and expressed as the amount (mL) of 0.1 mol L−1 NaOH to obtain a pH value of 8.2.
The colour coordinates (L*, a*, b*) were assessed using a CIELAB system (Chromameter CR-400, Konica Minolta, Tokyo, Japan).
For the evaluation of LAB count, 10 mL of the beverage were homogenised with 90 mL of saline (9 g L−1 NaCl solution). Serial dilutions of 10−4 to 10−8 with saline were used for sample preparation. Sterile MRS agar (CM0361, Oxoid) of 5 mm thickness was used for bacterial growth on Petri dishes. The dishes were separately seeded with the sample suspension using surface sowing and were incubated under anaerobic conditions at 30 °C for 72 h. All results were expressed in log10 CFU mL−1 (colony forming units per mL of the sample) as the mean of three determinations. To determine the viability of LAB during four weeks of storage at +4 °C.
2.6. Statistical Analysis
The results were expressed as the mean ± standard deviation (SD). All analyses were performed at least in triplicate. Results were analysed using statistical package SPSS for Windows V15.0 (SPSS Inc., Chicago, IL, USA, 2007). The significance of differences between the samples was evaluated using Tukey range tests at a 5% level. A linear Pearson’s correlation was used to quantify the strength of the relationship between the variables. The correlation coefficients were calculated using the statistical package SPSS. The results were recognised as statistically significant at p ≤ 0.05.
3. Results
3.1. Parameters of the Extruded Wheat Bran
Acidity (pH, total titratable acidity (TTA), and lactic acid isomers concentration) and microbiological parameters (lactic acid bacteria (LAB), mould/yeast (M/Y), total bacteria (TBC), and total enterobacteria (TEC) count) of the extruded and fermented WB are shown in Table 3. In comparing fermented and non-fermented WB samples, after 24 h of fermentation, the samples‘ pH was reduced by 28.9%, and TTA increased by 94.3%, in comparison with non-fermented extruded samples. L(+)/D(−) ratio in fermented WB samples was 1.35, with predominant L(+) lactic acid. Lactic acid bacteria (LAB) count in fermented samples was, on average, 8.79 log10 CFU g−1, however, significant reduction of M/Y count in fermented samples was not observed, compared with non-fermented ones. Enterobacteria did not remain in the fermented samples, however, extrusion was not a significant factor for TEC. Moreover, fermentation reduced sugar concentration in WB samples, and fructose, sucrose, and maltose did not remain after fermentation.
Table 3.
Acidity (pH, total titratable acidity (TTA), and lactic acid isomers concentration) and microbiological parameters (lactic acid bacteria (LAB), mould/yeast (M/Y), total bacteria (TBC), and total enterobacteria (TEC) count) of the extruded and fermented wheat bran.
Technological microorganisms, such as LAB, produce a variety of organic acids in the substrate and lower the pH to levels that are inhibitory to many pathogenic and opportunistic microorganisms [51]. The increases of TTA and the reduction of pH improves food safety parameters as well. The levels of pH and TTA in the substrate are influenced by many factors, including processing methods and product properties.
The major metabolite of LAB is D(−) and/or L(+) lactic acid [52]. However, the studies revealed the microbiota metabolism of D(−) and L(+) lactic acid in fermented products are scarce. Data on the ratio of lactic acid isomers was published for sauerkraut and cheese [53,54]. Different LAB showed different production ratios of D and L lactic acid [52,55]. The accumulation of D(−) lactic acid may cause D-lactic acidosis in mammals [56,57]. For this reason, researchers aimed to reduce the accumulation of D(−) isomers in fermented foods during the fermentation.
The contamination of foods during the various processes of the production chain is always the point of concern; this is especially important for the outer layer of cereals, which are contaminated from the field. Moreover, the occurrence of some fungal species can be a signal of mycotoxin contamination [58,59,60]. Different methods, including thermal and non-thermal, are used to decrease the bacterial, as well as fungal contamination of the cereal-based products [58,61]. The most environmentally-friendly and efficient methods for cereal decontamination are fermentation processes. In addition, fermentation leads to some positive nutritional and sensory characteristics of the products [61]. Moreover, during the extrusion process, which includes a combination of high temperature and high pressure, toxin, as well as non-desirable microorganisms reduction in food can be observed [62].
It was published that WB contamination (TBC) before fermentation was 5 log10 CFU g−1. For this reason, to ensure the stability of the fermentation process with L. rhamnosus 1473 strain, sterilisation step was included [63].
Finally, desirable changes in the fermented substrate were obtained: Fermentation reduced the sugar concentration and pH in the samples with predominant lactic acid isomer L(+), and also, the viable LAB count in the substrate was higher than 6.0 log10 CFU g−1 and enterobacteria did not remain.
The amino acids and biogenic amines (Bas) concentration in nontreated and extruded, as well as extruded and fermented cereal by-products, are shown in Table 4. Most of the analysed amino acids concentration after extrusion, as well as extrusion and fermentation in WB samples, remain similar as before treatment, however, some changes were established in glutamine, cysteine, tryptophan, phenylalanine and isoleucine content. Glutamine concentration in extruded and extruded/fermented WB samples was, on average, by 17.1% lower, compared with nontreated WB. An opposite tendency with cysteine concentration was found, and in comparison, nontreated and fermented/extruded WB samples, were on average, 15.0% higher in concentration in treated samples. However, tryptophan, phenylalanine, and isoleucine concentrations were reduced after extrusion and fermentation, on average, by 19.4, 21.4 and 20.0%, respectively. In opposite, lysine concentration in extruded and fermented samples was significantly higher (on average, by 23.5%).
Table 4.
The amino acids (g 100 g−1) and biogenic amines (mg kg−1) concentration in extruded and nontreated cereal by-products non-fermented and fermented with L. uvarum strain.
Despite the fact that WB fermentation is a very popular process in the food and feed industry, however published studies are very scarce [64,65,66], and it is worthy of note that about an extrusion and fermentation combination for WB treatment was never reported before [63].
Overall, WB is the main by-product of the wheat milling industry, containing more than 15% protein [67]. It was published that the proteins can be derived from WB [68]. Despite the fact that endosperm biological value is higher in comparison with bran, however, WB proteins have a more favourable amino acid composition compared to endosperm proteins [69]. However, these proteins are located within cell wall polysaccharides, and for this reason, its digestion is pure [70]. Compared to endosperm, WB proteins contain a higher amount of lysine, arginine, and glycine [71]. The most dominant amino acids in WB are glutamic and aspartic acids, leucine, alanine, proline, arginine, and glycine [70]. However, such a high content of protein in WB can lead to biogenic amines (BA) formation, especially, during the fermentation processes [72].
In comparing Bas concentration in WB, phenylethylamine, tyramine, and spermidine were not found in the tested WB samples. However, putrescine and spermine concentration in WB was increased after extrusion and extrusion/fermentation processes (in extruded samples by 33.6%, in extruded and fermented WB by 36.1% higher, in comparison with nontreated WB). Cadaverine and histamine were found just in the nontreated WB (on average, 41.33 and 63.64 mg kg−1, respectively). In opposite to putrescine, spermidine concentration after both treatments in WB was reduced (in extruded samples by 70.9%, in extruded and fermented WB by 70.1% lower, in compare with nontreated WB).
Bas are non-volatile nitrogenous bases with an aliphatic, aromatic structure formed by the decarboxylation of free amino acids [73,74,75]. Depending on chemical structures, Bas are aromatic amines (histamine, tyramine, β-phenylethylamine, tryptamine and serotonin), aliphatic diamines (putrescine and cadaverine), and aliphatic polyamines (agmatine, spermidine, and spermine). It has been published that BA antioxidant properties are stronger than those of some antioxidant vitamins [76]. BA concentrations varied widely within food types [74,77,78,79], and they can be influenced by stock origin, processing, storage technology etc. [74,77,80]. It should be pointed out that the consumption of foods high BA concentrations may be deleterious to human health; for this reason, it is very important to estimate concentrations of BA in foods [74,77,80]. Bas are stable compounds [74], however, it has been published that the milling process influences BA distribution in different cereal fractions [81]. It has been reported that whole-grain wheat contains greater amounts of polyamines in comparison with bread [82]. Confirmed results on the BA content in different fractions of cereal grains are limited, however, it is known that histamine, putrescine, cadaverine, tyramine, spermidine and spermine are responsible for toxicological effects of foods [81]. As low molecular weight compounds, after ingestion, they rapidly appear in the blood and various organs and are can inducing several digestive, circulatory and respiratory symptoms [74].
It has been published that BA concentration in durum wheat cultivars is considerable, but not so high as in fish, meat, cheese, fermented vegetables, soy products, and alcoholic beverages, etc. [73,74,79]. Finally, despite that the cereals have low BA content in comparison to the other foods, together with other high-BA foods, they can enhance allergic reactions [73,74]. To prevent the non-desirable effects of food, it is very important to control BA in a wide range of products [74].
3.2. Antimicrobial Properties of the Fruits/Berries by-Products
The antimicrobial properties of the fruit/berry by-products are shown in Table 5. Selected for this experiment, fruit/berry by-products (shepherd, raspberries, sea buckthorn, blueberries) did not show inhibition properties against Salmonella enterica Infantis and Kluyvera cryocrescens. Only raspberry by-products inhibited E. coli (hemolytic), Aeromonas veronii and Cronobacter sakazakii, with the diameter of inhibition zones (DIZ) being on average 12.9 mm. All the tested fruit/berry by-products inhibited Enterococcus durans, and the highest DIZ of the sea buckthorn against this pathogen was found (15.4 mm). Raspberries, sea buckthorn, and blueberries by-products showed antimicrobial properties against Bacillus pseudomycoides and Acinetobacter johnsonii, and the highest DIZ against both pathogens by raspberries by-products was found (on average, 15.4 mm). Staphylococcus aureus was inhibited by shepherd and blueberries by-products (DIZ, 13.3 and 9.2 mm, respectively). Hafnia alvei was inhibited by raspberries and blueberries by-products (DIZ 10.5 and 10.7 mm, respectively).
Table 5.
Antimicrobial properties of the fruit/berry by-products.
Sambucus nigra L. is well known because of its natural compounds, which reduces oxidative stress-induced diseases. Shepherd contains various organic acids, flavanol glycosides and anthocyanins [83,84]. The anthocyanins present in shepherd showed protective effects against influenza A and B virus and Helicobacter pylori infections [85,86,87], and work has been published about shepherd’s antifungal, antitumour [88,89,90,91,92,93,94] and antimicrobial properties [95]. The main compounds responsible for shepherd’s antimicrobial properties are polyphenols; extracts of shepherd possess antibacterial activity against E. coli and Pseudomonas pudita, however inhibition of Bacillus cereus and Staphylococcus aureus was not established in the literature.
Raspberry juice possesses antimicrobial and antifungal activity against Staphylococcus aureus, Escherichia coli, Proteus vulgaris, Pseudomonas aeruginosa, Bacillus subtilis, and Candida albicans. Antimicrobial activity of raspberries is explained by the presents of ellagitannins, whose content and composition may vary depending on the variety and geographical location, however, it has been published that raspberry extracts inhibited both Gram-positive and Gram-negative bacteria [96]. Sea buckthorn berries are rich in carotenoids, tocopherols, fatty acids, antioxidants, flavonoids, ascorbic and organic acids [97]. The main identified components are ascorbic acid, carotenoids and various phenolics, including proanthocyanins, gallic acid, ursolic acid, caffeic acid, cumaric acid, ferulic acid, catechin and epicatechin derivatives, quercetin, kaempferol, and isorhamnetin glycoside derivatives [98,99,100,101], which can be associated with pathogenic inhibition properties.
Blueberry fruits have revealed antimicrobial properties against Citrobacter freundii and Enterococcus faecalis [102]. It was published that blueberry leaves inhibited S. aureus, and this result can be related to high phenolic compounds content, which attacks an important number of bacteria, with the antimicrobial capacity depending on the interactions between polyphenols and bacterial cell surface [103,104]. R. equi was the most sensitive strain towards blueberry extracts, whereas E. faecalis Gram-positive strain was the most resistant one [105].
Fruit/berry by-products showed desirable antimicrobial activity: Shepherd inhibited 2, sea buckthorn—3, blueberries—5, and raspberries—7 pathogens from the 10 tested. Finally, in this study, shepherd by-products, and the obtained results showed that the tested by-products were very promising antimicrobial ingredients for nutraceuticals, pharmaceuticals, and food formulations.
3.3. Overall Acceptability and Emotions Induced for Consumers by the Prepared Enriched with Wheat Bran Beverages
The overall acceptability and emotions induced for consumers by the prepared beverages enriched with extruded and fermented wheat bran (WB) are shown in Table 6. Comparing the overall acceptability of the prepared beverages enriched with the different treated WB, the highest overall acceptability of the samples, prepared with 10 g of the extruded and fermented WB, is shown (7.9 points).
Table 6.
Overall acceptability and emotions induced for consumers by the prepared beverages enriched with extruded and fermented wheat bran.
Today, scientific interest focuses not just on food’s nutritional and functional value, but also on food-induced emotional responses, because, emotions are closely related to consumers’ food choices [106,107]. It has been published that the disliking of unknown and/or non-traditional foods is strongly related to negative emotions [108]. It is also known that positive emotions, such as joy, happiness, and satisfaction, have a significant positive correlation with food’s sensory properties [109]. According to Dalenberg et al. [110], emotional responses better-characterised food choices in comparison with liking. However, in comparison with other affective feelings, emotions were characterised by high intensity, rapid change, and were short-lasting [111].
In this study, between overall acceptability and the emotion “disgusted” was induced for consumers by the prepared beverages enriched with extruded and fermented WB, but very weak positive correlations were found (r = 0.1467), as well as weak positive correlations between overall acceptability and emotions “neutral”, “happy”, “sad”, and “angry” were found (r = 0.2430, r = 0.2105, r = 0.2705, and r = 0.2439, respectively). The strongest (positive moderate) correlation between the overall acceptability and emotion “scared” was found (r = 0.5295). According to the results obtained, for the further experiment, samples prepared with 10 g of the extruded and fermented WB was chosen, as they showed the highest overall acceptability.
3.4. Overall Acceptability and Emotions Induced for Consumers by the Prepared Beverages Enriched with Wheat Bran and Fruits/Berries By-Product Beverages
Overall acceptability and emotions induced for consumers by the prepared beverages enriched with extruded and fermented WB and fruit/berry by-products are shown in Table 7. In comparison, different beverage groups prepared with different types of berries, in most of the cases (except sea buckthorn), by increasing the berries’ content, the beverages’ overall acceptability was increased, and the highest overall acceptability of the samples, prepared with 5.0 and 7.5 g of blueberry by-products was found (on average, 9.5 points).
Table 7.
Overall acceptability and emotions induced for consumers by the prepared beverages enriched with extruded and fermented wheat bran and fruit/berry by-products.
Evaluation of the induced emotions by brands, packaging, etc. is generally performed to obtain information about product sales, brand loyalty, and consumer satisfaction [112]. However, the study of emotions induced by unpackaged foods and beverages in response to their sensory properties is more recent and very important for the development of product innovations [113,114]. It is suggested that the sensory properties of a product may correlate with emotions, and for this reason, a greater understanding of the relationship between sensory characteristics and emotions has become very important [115,116].
In this study, between overall acceptability and the emotion “happy” induced for consumers by the prepared beverages enriched with extruded and fermented WB and berries, there was a very strong positive correlations were found (r = 0.8525), as well as a strong negative correlation between overall acceptability and emotion “angry” was found (r = −0.6842). Moderate negative correlations between the overall acceptability and emotions “disgusted” and “contempt” were found (r = −0.4134 and r = −0.4134, respectively). Between overall acceptability and emotions “neutral” and “sad” very weak positive correlations were found (r = 0.1136 and r = 0.1973, respectively). According to overall acceptability results, for the further experiments, samples prepared with 20 g 50 mL−1 of WB and with the addition of 5.0 g 50 mL−1 of sea buckthorn and 7.5 g 50 mL−1 of shepherd, raspberries and blueberries were selected.
In the last decade, evaluation of emotions has been widely applied by the beverage industry in the product development cycle, for product improvement and optimisation, and changes in the formulation [117,118]. However, the literature in this area of application is scarce, since most manufacturers use this information internally to achieve a technical advantage against other competitors in the market [117]. Thomson et al. [119] published that specific sensory characteristics are associated with emotional conceptualisations in unbranded samples of dark chocolate, including associations of “cocoa” with “powerful” and “energetic”, “bitter” with “confident”, “adventurous” and “masculine”, and “creamy” and “sweet” with “fun”, “comforting” and “easy-going”. However, Thomson et al. did not compare hedonic and emotional responses; for this reason, it is not possible to determine sensory-emotion linkages. However, a correlation between acceptability and emotional associations in food and beverages was reported [114,120,121,122,123,124].
In this study, also, a very strong positive correlation was found between overall acceptability and the emotion “happy”, however, it should be mentioned that the beverages without fruit/berry by-products showed lower correlations between overall acceptability and induced emotions. It could be that more intensive sensory properties induced by the addition of fruit/berry by-products, induced stronger emotions for consumers, which were fixed, and in this study, by fruit/berry by-products induced emotions were positive.
3.5. Antimicrobial Activity of the Prepared Beverages Enriched with Wheat Bran and Fruits/Berries By-Products
The DIZ of the prepared beverages against pathogenic and opportunistic strains are shown in Table 8. All of the prepared beverages showed inhibition properties against Salmonella enterica Infantis and Staphylococcus aureus, however, all of the prepared beverages did not inhibit Kluyvera cryocrescens. Beverages, prepared with extruded and fermented WB, but without berries/fruits by-products inhibited 2 out of 10 tested pathogenic and opportunistic strains, however, beverages prepared with shepherd and sea buckthorn inhibited 9 out of 10, as well as beverages prepared with raspberry and blueberry by-products, which inhibited 8 out of 10 tested pathogenic and opportunistic strains. The highest DIZ of beverages prepared with shepherd against E. coli (hemolytic) and Enterococcus durans were found (13.4 and 12.3 mm, respectively), the highest DIZ of beverages prepared with raspberry by-products against Bacillus pseudomycoides, Enterococcus durans, and Acinetobacter johnsonii (DIZ, on average, 13.8 mm), the highest DIZ of beverages prepared with sea buckthorn by-products against Enterococcus durans and Acinetobacter johnsonii (DIZ, on average, 13.9 mm), and the highest DIZ of beverages prepared with blueberry by-products against E. coli (hemolytic) and Enterococcus durans (DIZ, on average, 14.8 mm).
Table 8.
The diameter of inhibition zones (mm) of the prepared beverages against pathogenic and opportunistic strains.
Finally, in all the cases, berries/fruits by-products increase beverages’ antimicrobial properties, in comparison with beverages prepared just with extruded and fermented WB, and these results can be related to berries/fruits’ bioactive compounds and antimicrobial properties, which are described above (Section 3.2). Moreover, during fermentation, LAB excreted a broad spectrum of antimicrobial compounds (organic acids, low molecular weight peptides, hydrogen peroxide, etc.) that inhibits the growth of pathogenic and opportunistic strains [125]. The antimicrobial activity of LAB against a variety of pathogenic and opportunistic strains was determined in several studies [126,127,128,129,130,131]. In the developed beverages, both antimicrobial ingredients: Viable LAB and fruit/berry by-products showed a symbiotic effect on pathogens inhibition.
3.6. LAB Count during the Storage, Colour Coordinates, and Acidity Parameters
The viable LAB count in prepared beverages during the four weeks of storage at +4 °C temperature is shown in Table 9. The LAB count after 24 h in beverages was, on average, 8.17 log10 CFU mL−1, and after one and two weeks of storage, significant changes in the LAB counts were not found. However, after three weeks of storage, LAB count was reduced in the fermented milk permeate (without WB and berries/fruits by-products addition) samples (on average, by 10.3%). After four weeks of storage, higher than 6.0 log10 CFU mL−1 remain in two beverage groups: Beverages prepared with extruded and fermented WB (on average, 7.20 log10 CFU mL−1) and in beverages prepared with extruded and fermented WB and 7.5 g 50 mL−1 of shepherd (on average, 6.93 log10 CFU mL−1). Finally, three weeks storage time for beverages can be recommended, because during this time the viable LAB count in beverages remained higher than 6.0 log10 CFU mL−1. In addition, the beverages prepared with extruded and fermented WB, and beverages prepared with extruded and fermented WB and 7.5 g 50 mL−1 of shepherd had their functional properties retained for longer, and for the above-mentioned beverages, four weeks storage time can be recommended.
Table 9.
Viable lactic acid bacteria (LAB) count in prepared beverages during the four weeks of storage storage at +4 °C temperature.
Colour coordinates, acidity and antioxidant parameters of the prepared beverages are shown in Table 10.
Table 10.
Colour coordinates, acidity and antioxidant parameters of the prepared beverages.
The highest lightness (L*) coordinates of the beverages prepared with extruded and fermented WB were established (39.1 NBS), the lowest L* (by 49.6% lower) of the beverages, prepared with WB and shepherd addition were found. The addition of raspberries increases redness (a*) of beverages, and in comparison with beverages groups with and without berries, beverages with raspberries had a* coordinates that were by 88.0 and 63.5% higher, respectively. The highest yellowness (b*) of the beverages prepared with the sea buckthorn was found (15.5 NBS), and in comparison with other beverages, this group showed, on average, 7.7 times higher b* coordinates. Colour characteristics are one from the main sensory properties, which have a strong relationship with consumers’ acceptance and purchasing decisions regarding a product [132]. In addition, colour is a product quality indicator and influences the perception of taste, safety, as well as nutritional value [133].
Moderate positive correlations between overall acceptability and L*, between emotion “sad” and a*, and between the emotion “disgusted” and L* were found (Table 11). As well as moderate negative correlations between emotion “angry” and a*, it was also established between the emotion “surprised” and a* and b* colour coordinates. In addition, there were strong positive correlations between the emotion “neutral” and L*, between the emotion “happy” and a*, between the emotion “contempt” and a*, and between “valence” and a* and b* coordinates. The strong negative correlation between emotion “happy” and L* was established, as well as a very strong positive correlation between the emotion “sad” and b* and between emotion “contempt” and b*.
Table 11.
Correlation coefficients between colour coordinates and overall acceptability and emotions induced for consumers by the tested beverages.
In a comparison of the pH of the beverages prepared with functional additives, the lowest pH of the samples prepared with raspberries and blueberries was found to be 4.17 and 4.20, respectively, but it should be mentioned, that all the samples prepared with additives showed a higher pH than that fermented milk permeate (pH 3.91) without WB and/or fruits/berries. A very strong negative correlation was found between pH and TTA of the samples (r = –0.94524). In comparison, with total phenolic compound (TPC) content in samples, the highest TPC content in beverages prepared with the addition of raspberries was established (141.7 mg 100 g−1 d.m.). The lowest TPC content in non-fermented milk permeate was found (68.2 mg 100 g−1 d.m.), however, fermentation increased TPC in milk permeate samples, on average, by 34.9%, compared with samples prepared with extruded and fermented WB with fermented milk permeate without additives, where WB addition increased TPC content, on average, by 15.8%. When comparing the samples group prepared with the addition of extruded and fermented WB with samples prepared with WB and fruit/berry by-products, most fruits/berry by-products increased TPC content in the beverages (on average, by 9.0%), except samples prepared with sea buckthorn, in which TPC remained similar as before the addition of fruit/berry by-products. A very high positive correlation was established Between TPC and antioxidant activity of the samples (r = 0.9919).
The development of plant-derived nutraceutical beverages with antioxidant properties has been the intensively studied in recent years [134]. In this study, the main antioxidant properties in the developed beverages’ ingredients were fruit/berry by-products, however, it should be mentioned that the LAB also excreted antioxidant property possessing compounds.
The modulation of the intestinal redox environment using viable bacteria possessing antioxidant properties has also been noted [135].
The health benefits of products containing desirable bioactive compounds have been previously published. Antioxidant characteristics of plants can be related to several anti-oxidative mechanisms of the chemical composition of plant tissues, as well as by micro- and macrocompounds interactions, including synergistic or opposite mechanisms of action [136].
The main compounds, which lead to shepherd antioxidant activity, are anthocyanins and flavanols [137]. Shepherd phenolics are depended on plant genetic differences, environmental conditions, degree of maturity, etc., and these factors are very important for industry because chemical composition is related to antioxidant capacity [138]. Raspberries are a good source of bioactive phytochemicals, especially phenolics, in which the general structure contains an aromatic ring with one or more hydroxyl groups, and these compounds are highly associated with antioxidant capacity [139]. The antioxidant capacity of phenolics is based on the ability of the phenolic ring to stabilise and delocalise unpaired electrons [140].
TPC in raspberries varied between 142 and 758 mg gallic acid equivalents (GAE) 100 g−1 fw [29]. The concentration of TPC in plants can be induced by many factors, including species, cultivar, ripening stage, soil, and climate [141,142], producing differences in the TPC found among the different studied species [96]. Moreover, in vitro antioxidant activity of the fruit/berries can be related to the high content of ascorbic acid [143,144,145]. It was reported that Sea buckthorns are rich in phenolics and flavonoids with potential antioxidant and antiproliferative activities and can be recommended in antioxidant and anticancer dietary supplement synthesis and utilisation in the food industry. Furthermore, it was published about blueberry antioxidant activity [102]. The effect of blueberry juice phytochemicals occurs through redox- and non-redox-regulated mechanisms and protects from oxidative damage factors related to bone remodelling and bone formation [146].
4. Conclusions
This study confirms that added-value products can be prepared from food industry by-products combinations. However, it should be mentioned that ingredients quantities and their pre-treatment must be carefully selected. In this study, in most cases (except sea buckthorn), by increasing FBB content the beverages overall acceptability was increased, and the highest was obtained for the samples prepared with 5.0 and 7.5 g of blueberries FBB. A very strong positive correlation (r = 0.8525) between overall acceptability, evaluated by points, and emotion “happy”, induced for consumers by the prepared beverages, was found. Moreover, FBB is a good source to increase total phenolic compounds (TPC) content (in this study, on average, by 9.0%) in beverages. Finally, it can be stated that newly developed nutraceutical beverages are acceptable for consumers, induced positive emotions, as well as possessing desirable antimicrobial and antioxidant properties, and are prepared in an environmentally friendly and sustainable manner.
Author Contributions
Conceptualization and methodology: E.Z., E.B., R.P.F.G., M.R. and P.V.; investigation: E.Z., D.C., D.K., V.L., V.S. (Vytaute Starkute), P.Z., J.A., A.B., M.D., K.S. and S.T.; writing—original draft preparation: E.Z., D.C., V.L., V.S. (Vesta Steibliene) and P.Z.; writing—review and editing: E.B., R.P.F.G. and M.R.; visualization: E.Z., V.S. (Vesta Steibliene), P.Z., V.L. and P.V.; supervision: E.B. All authors have read and agreed to the published version of the manuscript.
Funding
This research received no external funding.
Acknowledgments
The authors gratefully acknowledge the EUREKA Network Project E!13309 “SUSFEETECH” (No. 01.2.2-MITA-K-702-05-0001) and COST Action 18101 SOURDOMICS—Sourdough biotechnology network towards novel, healthier and sustainable food and bioprocesses (https://sourdomics.com/; https://www.cost.eu/actions/CA18101/).
Conflicts of Interest
The authors declare no conflict of interest.
References
- Sustainable Food Environment European Commission. Available online: https://ec.europa.eu/environment/archives/eussd/food.htm (accessed on 13 June 2020).
- Meiselman, H.L. Emotions of Eating and Drinking. In Handbook of Eating and Drinking: Interdisciplinary Perspectives; Meiselman, H.L., Ed.; Springer International Publishing: Cham, Switzerland, 2020; pp. 349–370. ISBN 978-3-030-14504-0. [Google Scholar]
- Bartkiene, E.; Steibliene, V.; Adomaitiene, V.; Lele, V.; Cernauskas, D.; Zadeike, D.; Klupsaite, D.; Juodeikiene, G. Corrigendum: The Perspectives Associated with the Computer-Based Diagnostic Method of Depressive Disorder. Front. Psychiatry 2019, 10, 10. [Google Scholar] [CrossRef] [PubMed]
- Food Processing Industry-An Overview Science Direct Topics. Available online: https://www.sciencedirect.com/topics/earth-and-planetary-sciences/food-processing-industry (accessed on 2 July 2020).
- Zokaityte, E.; Cernauskas, D.; Klupsaite, D.; Lele, V.; Starkute, V.; Zavistanaviciute, P.; Ruzauskas, M.; Gruzauskas, R.; Juodeikiene, G.; Rocha, J.; et al. Bioconversion of Milk Permeate with Selected Lactic Acid Bacteria Strains and Apple By-Products into Beverages with Antimicrobial Properties and Enriched with Galactooligosaccharides. Microorganisms 2020, 8, 1182. [Google Scholar] [CrossRef] [PubMed]
- Fernández, J.; Moreno, F.J.; Olano, A.; Clemente, A.; Villar, C.J.; Lombó, F. A Galacto-Oligosaccharides Preparation Derived from Lactulose Protects Against Colorectal Cancer Development in an Animal Model. Front. Microbiol. 2018, 9, 2004. [Google Scholar] [CrossRef] [PubMed]
- Germec, M.; Tarhan, K.; Yatmaz, E.; Tetik, N.; Karhan, M.; Demirci, A.; Turhan, I. Ultrasound-assisted dilute acid hydrolysis of tea processing waste for production of fermentable sugar. Biotechnol. Prog. 2016, 32, 393–403. [Google Scholar] [CrossRef] [PubMed]
- Knauf, M.; Moniruzzaman, M. Lignocellulosic biomass processing: A perspective. Int. Sugar J. 2004, 106, 147–150. [Google Scholar]
- Menon, V.; Rao, M. Trends in bioconversion of lignocellulose: Biofuels, platform chemicals & biorefinery concept. Prog. Energy Combust. Sci. 2012, 38, 522–550. [Google Scholar] [CrossRef]
- Sharma, P.; Gujral, H.S.; Singh, B. Antioxidant activity of barley as affected by extrusion cooking. Food Chem. 2012, 131, 1406–1413. [Google Scholar] [CrossRef]
- Germec, M.; Ozcan, A.; Turhan, I. Bioconversion of wheat bran into high value-added products and modelling of fermentations. Ind. Crop. Prod. 2019, 139, 111565. [Google Scholar] [CrossRef]
- Guillon, F.; Champ, M. Structural and physical properties of dietary fibres, and consequences of processing on human physiology. Food Res. Int. 2000, 33, 233–245. [Google Scholar] [CrossRef]
- Yang, Q.; Huang, X.; Zhao, S.; Sun, W.; Yan, Z.; Wang, P.; Li, S.; Huang, W.; Zhang, S.; Liu, L.; et al. Structure and Function of the Fecal Microbiota in Diarrheic Neonatal Piglets. Front. Microbiol. 2017, 8, 502. [Google Scholar] [CrossRef]
- Gualberto, D.G.; Bergman, C.J.; Kazemzadeh, M.; Weber, C.W. Effect of extrusion processing on the soluble and insoluble fiber, and phytic acid contents of cereal brans. Plant Foods Hum. Nutr. 1997, 51, 187–198. [Google Scholar] [CrossRef]
- Ralet, M.-C.; Thibault, J.-F.; Della Valle, G. Influence of extrusion-cooking on the physico-chemical properties of wheat bran. J. Cereal Sci. 1990, 11, 249–259. [Google Scholar] [CrossRef]
- Kaur, J.; Debnath, J. Autophagy at the crossroads of catabolism and anabolism. Nat. Rev. Mol. Cell Biol. 2015, 16, 461–472. [Google Scholar] [CrossRef] [PubMed]
- Applequist, W. A Brief Review of Recent Controversies in the Taxonomy and Nomenclature of Sambucus Nigra Sensu Lato. Acta Hortic. 2015, 1061, 25–33. [Google Scholar] [CrossRef][Green Version]
- Charlebois, D.; Byers, P.L.; Finn, C.E.; Thomas, A.L. Elderberry: Botany, Horticulture, Potential; Horticultural Reviews; Wiley: Hoboken, NJ, USA, 2010; Volume 37, pp. 213–280. [Google Scholar]
- Manganelli, R.E.U.; Zaccaro, L.; Tomei, P. Antiviral activity in vitro of Urtica dioica L., Parietaria diffusa M. et K. and Sambucus nigra L. J. Ethnopharmacol. 2005, 98, 323–327. [Google Scholar] [CrossRef] [PubMed]
- Lee, J.; Finn, C.E. Anthocyanins and other polyphenolics in American elderberry (Sambucus canadensis) and European elderberry (S. nigra) cultivars. J. Sci. Food Agric. 2007, 87, 2665–2675. [Google Scholar] [CrossRef]
- Fazio, A.; Plastina, P.; Meijerink, J.; Witkamp, R.F.; Gabriele, B. Comparative analyses of seeds of wild fruits of Rubus and Sambucus species from Southern Italy: Fatty acid composition of the oil, total phenolic content, antioxidant and anti-inflammatory properties of the methanolic extracts. Food Chem. 2013, 140, 817–824. [Google Scholar] [CrossRef] [PubMed]
- Sidor, A.; Gramza-Michałowska, A. Advanced research on the antioxidant and health benefit of elderberry (Sambucus nigra) in food—A review. J. Funct. Foods 2015, 18, 941–958. [Google Scholar] [CrossRef]
- Viapiana, A.; Wesołowski, M. The Phenolic Contents and Antioxidant Activities of Infusions of Sambucus nigra L. Plant Foods Hum. Nutr. 2017, 72, 82–87. [Google Scholar] [CrossRef]
- Dawidowicz, A.L.; Wianowska, D.; Baraniak, B. The antioxidant properties of alcoholic extracts from Sambucus nigra L. (antioxidant properties of extracts). LWT 2006, 39, 308–315. [Google Scholar] [CrossRef]
- Paredes-López, O.; Cervantes-Ceja, M.L.; Vigna-Pérez, M.; Hernández-Pérez, T. Berries: Improving Human Health and Healthy Aging, and Promoting Quality Life—A Review. Plant Foods Hum. Nutr. 2010, 65, 299–308. [Google Scholar] [CrossRef]
- Konieczynski, P.; Arceusz, A.; Wesolowski, M. Essential Elements and Their Relations to Phenolic Compounds in Infusions of Medicinal Plants Acquired from Different European Regions. Biol. Trace Element Res. 2015, 170, 466–475. [Google Scholar] [CrossRef] [PubMed]
- Teng, J.; Jakeman, A.; Vaze, J.; Croke, B.; Dutta, D.; Kim, S. Flood inundation modelling: A review of methods, recent advances and uncertainty analysis. Environ. Model. Softw. 2017, 90, 201–216. [Google Scholar] [CrossRef]
- Bowen-Forbes, C.S.; Zhang, Y.; Nair, M.G. Anthocyanin content, antioxidant, anti-inflammatory and anticancer properties of blackberry and raspberry fruits. J. Food Compos. Anal. 2010, 23, 554–560. [Google Scholar] [CrossRef]
- De Souza, V.R.; Pereira, P.A.P.; Da Silva, T.L.T.; Lima, L.C.D.O.; Pio, R.; Queiroz, F. Determination of the bioactive compounds, antioxidant activity and chemical composition of Brazilian blackberry, red raspberry, strawberry, blueberry and sweet cherry fruits. Food Chem. 2014, 156, 362–368. [Google Scholar] [CrossRef]
- Sariburun, E.; Şahin, S.; Demir, C.; Türkben, C.; Uylaşer, V. Phenolic Content and Antioxidant Activity of Raspberry and Blackberry Cultivars. J. Food Sci. 2010, 75, C328–C335. [Google Scholar] [CrossRef]
- Bobinaitė, R.; Pataro, G.; Lamanauskas, N.; Šatkauskas, S.; Viškelis, P.; Ferrari, G. Application of pulsed electric field in the production of juice and extraction of bioactive compounds from blueberry fruits and their by-products. J. Food Sci. Technol. 2015, 52, 5898–5905. [Google Scholar] [CrossRef]
- Diaconeasa, Z.; Florica, R.; Rugină, D.; Lucian, C.; Carmen, S. HPLC/PDA–ESI/MS Identification of Phenolic Acids, Flavonol Glycosides and Antioxidant Potential in Blueberry, Blackberry, Raspberries and Cranberries. J. Food Nutr. Res. 2014, 2, 781–785. [Google Scholar] [CrossRef]
- Kula, M.; Majdan, M.; Głód, D.; Krauze-Baranowska, M. Phenolic composition of fruits from different cultivars of red and black raspberries grown in Poland. J. Food Compos. Anal. 2016, 52, 74–82. [Google Scholar] [CrossRef]
- Mullen, W.; McGinn, J.; Lean, M.E.J.; MacLean, M.R.; Gardner, P.; Duthie, G.G.; Yokota, T.; Crozier, A. Ellagitannins, Flavonoids, and Other Phenolics in Red Raspberries and Their Contribution to Antioxidant Capacity and Vasorelaxation Properties. J. Agric. Food Chem. 2002, 50, 5191–5196. [Google Scholar] [CrossRef]
- Sytařová, I.; Orsavová, J.; Snopek, L.; Mlček, J.; Byczyński, Ł.; Mišurcová, L. Impact of phenolic compounds and vitamins C and E on antioxidant activity of sea buckthorn (Hippophaë rhamnoides L.) berries and leaves of diverse ripening times. Food Chem. 2020, 310, 125784. [Google Scholar] [CrossRef] [PubMed]
- Araya-Farias, M.; Makhlouf, J.; Ratti, C. Drying of Seabuckthorn (Hippophae rhamnoides L.) Berry: Impact of Dehydration Methods on Kinetics and Quality. Dry. Technol. 2011, 29, 351–359. [Google Scholar] [CrossRef]
- Arif, S.; Ahmed, S.; Shah, A.; Hassan, L.; Awan, S.I.; Hamid, A.; Batool, F. Determination of optimum harvesting time for vitamin C, oil and mineral elements in berries sea buckthorn (Hippophae rhamnoides). Pak. J. Bot. 2010, 42, 3561–3568. [Google Scholar]
- Fatima, T.; Kesari, V.; Watt, I.; Wishart, D.S.; Todd, J.F.; Schroeder, W.R.; Paliyath, G.; Krishna, P. Metabolite profiling and expression analysis of flavonoid, vitamin C and tocopherol biosynthesis genes in the antioxidant-rich sea buckthorn (Hippophae rhamnoides L.). Phytochemistry 2015, 118, 181–191. [Google Scholar] [CrossRef]
- Stobdan, T.; Korekar, G.; Srivastava, R.B. Nutritional Attributes and Health Application of Seabuckthorn (Hippophae rhamnoides L.) A Review. Curr. Nutr. Food Sci. 2013, 9, 151–165. [Google Scholar] [CrossRef]
- Tiitinen, K.; Yang, B.; Haraldsson, G.G.; Jonsdottir, S.; Kallio, H.P. Fast Analysis of Sugars, Fruit Acids, and Vitamin C in Sea Buckthorn (Hippophaë rhamnoides L.) Varieties. J. Agric. Food Chem. 2006, 54, 2508–2513. [Google Scholar] [CrossRef]
- Beveridge, T.; Li, T.S.C.; Oomah, B.D.; Smith, A. Sea Buckthorn Products: Manufacture and Composition. J. Agric. Food Chem. 1999, 47, 3480–3488. [Google Scholar] [CrossRef] [PubMed]
- Liu, S.; Marsol-Vall, A.; Laaksonen, O.; Kortesniemi, M.; Yang, B. Characterization and Quantification of Nonanthocyanin Phenolic Compounds in White and Blue Bilberry (Vaccinium myrtillus) Juices and Wines Using UHPLC-DAD−ESI-QTOF-MS and UHPLC-DAD. J. Agric. Food Chem. 2020, 68, 7734–7744. [Google Scholar] [CrossRef]
- Pires, T.C.S.P.; Caleja, C.; Buelga, C.S.; Barros, L.; Ferreira, I.C. Vaccinium myrtillus L. Fruits as a Novel Source of Phenolic Compounds with Health Benefits and Industrial Applications-A Review. Curr. Pharm. Des. 2020, 26, 1917–1928. [Google Scholar] [CrossRef]
- Elias, M.; Madureira, J.; Santos, P.; Carolino, M.; Margaça, F.; Verde, S.C. Preservation treatment of fresh raspberries by e-beam irradiation. Innov. Food Sci. Emerg. Technol. 2020, 66, 102487. [Google Scholar] [CrossRef]
- Bartkiene, E. Possible Uses of Lactic acid Bacteria for Food and Feed Production. Agric. Res. Technol. Open Access J. 2017, 4, 4. [Google Scholar] [CrossRef]
- Bartkiene, E.; Bartkevics, V.; Starkute, V.; Krungleviciute, V.; Cizeikiene, D.; Zadeike, D.; Juodeikiene, G.; Maknickiene, Z. Chemical composition and nutritional value of seeds of Lupinus luteus L., L. angustifolius L. and new hybrid lines of L. angustifolius L. Zemdirb. Agric. 2016, 103, 107–116. [Google Scholar] [CrossRef]
- Ben-Gigirey, B.; De Sousa, J.M.V.B.; Villa, T.G.; Barros-Velazquez, J. Histamine and Cadaverine Production by Bacteria Isolated from Fresh and Frozen Albacore (Thunnus alalunga). J. Food Prot. 1999, 62, 933–939. [Google Scholar] [CrossRef] [PubMed]
- Bartkiene, E.; Bartkevičs, V.; Rusko, J.; Starkute, V.; Bendoraitiene, E.; Zadeike, D.; Juodeikiene, G. The effect of Pediococcus acidilactici and Lactobacillus sakei on biogenic amines formation and free amino acid profile in different lupin during fermentation. LWT 2016, 74, 40–47. [Google Scholar] [CrossRef]
- 14:00–17:00 ISO 8586-1:1993. Available online: https://www.iso.org/cms/render/live/en/sites/isoorg/contents/data/standard/01/58/15875.html (accessed on 18 September 2020).
- Bartkiene, E.; Zokaityte, E.; Lele, V.; Sakiene, V.; Zavistanaviciute, P.; Klupsaite, D.; Bendoraitiene, J.; Navikaite-Snipaitiene, V.; Ruzauskas, M. Technology and characterisation of whole hemp seed beverages prepared from ultrasonicated and fermented whole seed paste. Int. J. Food Sci. Technol. 2019, 55, 406–419. [Google Scholar] [CrossRef]
- Sanni, A. The need for process optimization of African fermented foods and beverages. Int. J. Food Microbiol. 1993, 18, 85–95. [Google Scholar] [CrossRef]
- Garvie, I.E. Bacterial lactate dehydrogenases. Microbiol. Rev. 1980, 44, 106–139. [Google Scholar] [CrossRef]
- Jin, Y.; Compaan, A.; Bhattacharjee, T.; Huang, Y. Granular gel support-enabled extrusion of three-dimensional alginate and cellular structures. Biofabrication 2016, 8, 025016. [Google Scholar] [CrossRef]
- Mozuriene, E.; Bartkiene, E.; Juodeikiene, G.; Žadeikė, D.; Basinskiene, L.; Maruška, A.; Stankevičius, M.; Ragažinskienė, O.; Damašius, J.; Cizeikiene, D. The effect of savoury plants, fermented with lactic acid bacteria, on the microbiological contamination, quality, and acceptability of unripened curd cheese. LWT 2016, 69, 161–168. [Google Scholar] [CrossRef]
- Manome, A.; Okada, S.; Uchimura, T.; Komagata, K. The ratio of L-form to D-form of lactic acid as a criteria for the identification of lactic acid bacteria. J. Gen. Appl. Microbiol. 1998, 44, 371–374. [Google Scholar] [CrossRef] [PubMed]
- Kowlgi, N.G.; Chhabra, L. D-Lactic Acidosis: An Underrecognized Complication of Short Bowel Syndrome. Gastroenterol. Res. Pr. 2015, 2015, 1–8. [Google Scholar] [CrossRef]
- Monroe, G.R.; Van Eerde, A.M.; Tessadori, F.; Duran, K.J.; Savelberg, S.M.C.; Van Alfen, J.C.; Terhal, P.A.; Van Der Crabben, S.N.; Lichtenbelt, K.D.; Fuchs, S.A.; et al. Identification of human D lactate dehydrogenase deficiency. Nat. Commun. 2019, 10, 1477. [Google Scholar] [CrossRef]
- Khaneghah, A.M.; Moosavi, M.H.; Oliveira, C.A.; Vanin, F.; Sant’Ana, A.S. Electron beam irradiation to reduce the mycotoxin and microbial contaminations of cereal-based products: An overview. Food Chem. Toxicol. 2020, 143, 111557. [Google Scholar] [CrossRef]
- Heshmati, A.; Zohrevand, T.; Khaneghah, A.M.; Nejad, A.S.M.; Sant’Ana, A.S. Co-occurrence of aflatoxins and ochratoxin A in dried fruits in Iran: Dietary exposure risk assessment. Food Chem. Toxicol. 2017, 106, 202–208. [Google Scholar] [CrossRef]
- Khaneghah, A.M.; Fakhri, Y.; Sant’Ana, A.S. Impact of unit operations during processing of cereal-based products on the levels of deoxynivalenol, total aflatoxin, ochratoxin A, and zearalenone: A systematic review and meta-analysis. Food Chem. 2018, 268, 611–624. [Google Scholar] [CrossRef]
- Zhu, C.; Bortesi, L.; Baysal, C.; Twyman, R.; Fischer, R.; Capell, T.; Schillberg, S.; Christou, P. Characteristics of Genome Editing Mutations in Cereal Crops. Trends Plant Sci. 2017, 22, 38–52. [Google Scholar] [CrossRef] [PubMed]
- Peng, X.; Zhang, S.; Li, L.; Zhao, X.; Ma, Y.; Shi, D. Long-term high-solids anaerobic digestion of food waste: Effects of ammonia on process performance and microbial community. Bioresour. Technol. 2018, 262, 148–158. [Google Scholar] [CrossRef]
- Spaggiari, M.; Ricci, A.; Calani, L.; Bresciani, L.; Neviani, E.; Dall’Asta, C.; Lazzi, C.; Galaverna, G. Solid state lactic acid fermentation: A strategy to improve wheat bran functionality. LWT 2020, 118, 108668. [Google Scholar] [CrossRef]
- Arte, E.; Rizzello, C.G.; Verni, M.; Nordlund, E.; Katina, K.; Coda, R. Impact of Enzymatic and Microbial Bioprocessing on Protein Modification and Nutritional Properties of Wheat Bran. J. Agric. Food Chem. 2015, 63, 8685–8693. [Google Scholar] [CrossRef]
- Messia, M.; Reale, A.; Maiuro, L.; Candigliota, T.; Sorrentino, E.; Marconi, E. Effects of pre-fermented wheat bran on dough and bread characteristics. J. Cereal Sci. 2016, 69, 138–144. [Google Scholar] [CrossRef]
- Prückler, M.; Lorenz, C.; Endo, A.; Kraler, M.; Dürrschmid, K.; Hendriks, K.; Silva, F.; Auterith, E.; Kneifel, W.; Michlmayr, H. Comparison of homo and heterofermentative lactic acid bacteria for implementation of fermented wheat bran in bread. Food Microbiol. 2015, 49, 211–219. [Google Scholar] [CrossRef]
- Laddomada, B.; Caretto, S.; Mita, G. Wheat Bran Phenolic Acids: Bioavailability and Stability in Whole Wheat-Based Foods. Molecules 2015, 20, 15666–15685. [Google Scholar] [CrossRef]
- De Brier, N.; Gomand, S.V.; Donner, E.; Paterson, D.; Delcour, J.A.; Lombi, E.; Smolders, E. Distribution of Minerals in Wheat Grains (Triticum aestivum L.) and in Roller Milling Fractions Affected by Pearling. J. Agric. Food Chem. 2015, 63, 1276–1285. [Google Scholar] [CrossRef] [PubMed]
- Di Lena, G.; Vivanti, V.; Quaglia, G.B. Amino acid composition of wheat milling by-products after bioconversion by edible fungi mycelia. Food/Nahrung 1997, 41, 285–288. [Google Scholar] [CrossRef]
- Balandrán-Quintana, R.R.; Mercado-Ruiz, J.N.; Mendoza-Wilson, A.M. Wheat Bran Proteins: A Review of Their Uses and Potential. Food Rev. Int. 2015, 31, 279–293. [Google Scholar] [CrossRef]
- Zhu, K.; Huang, S.; Peng, W.; Qian, H.; Zhou, H.-M. Effect of ultrafine grinding on hydration and antioxidant properties of wheat bran dietary fiber. Food Res. Int. 2010, 43, 943–948. [Google Scholar] [CrossRef]
- Alzuwaid, N.T.; Sissons, M.; Laddomada, B.; Fellows, C.M. Nutritional and functional properties of durum wheat bran protein concentrate. Cereal Chem. J. 2019, 97, 304–315. [Google Scholar] [CrossRef]
- Feddern, V.; Mazzuco, H.; Fonseca, F.N.; De Lima, G.J.M.M. A review on biogenic amines in food and feed: Toxicological aspects, impact on health and control measures. Anim. Prod. Sci. 2019, 59, 608. [Google Scholar] [CrossRef]
- Ruiz-Capillas, C.; Herrero, A.M. Impact of Biogenic Amines on Food Quality and Safety. Foods 2019, 8, 62. [Google Scholar] [CrossRef]
- Wink, M. Modes of Action of Herbal Medicines and Plant Secondary Metabolites. Medicines 2015, 2, 251–286. [Google Scholar] [CrossRef] [PubMed]
- Ali, M.A.; Poortvliet, E.; Strömberg, R.; Yngve, A. Polyamines in foods: Development of a food database. Food Nutr. Res. 2011, 55, 5572. [Google Scholar] [CrossRef]
- Buyukuslu, N.; Hizli, H.; Esin, K.; Garipagaoglu, M. A Cross-Sectional Study: Nutritional Polyamines in Frequently Consumed Foods of the Turkish Population. Foods 2014, 3, 541–557. [Google Scholar] [CrossRef]
- Gg, H.; Gd, H.; Az, W. Effect of Refined Milling on the Nutritional Value and Antioxidant Capacity of Wheat Types Common in Ethiopia and a Recovery Attempt with Bran Supplementation in Bread. J. Food Process. Technol. 2015, 6, 6. [Google Scholar] [CrossRef]
- Ladero, V.; Calles-Enriquez, M.; Fernandez, M.; Alvarez, M.A. Toxicological Effects of Dietary Biogenic Amines. Curr. Nutr. Food Sci. 2010, 6, 145–156. [Google Scholar] [CrossRef]
- Ozogul, F.; Ozogul, Y. Biogenic amine content and biogenic amine quality indices of sardines (Sardina pilchardus) stored in modified atmosphere packaging and vacuum packaging. Food Chem. 2006, 99, 574–578. [Google Scholar] [CrossRef]
- Karayigit, B.; Colak, N.; Ozogul, F.; Gundogdu, A.; Inceer, H.; Bilgiçli, N.; Ayaz, F.A. The biogenic amine and mineral contents of different milling fractions of bread and durum wheat (Triticum L.) cultivars. Food Biosci. 2020, 37, 100676. [Google Scholar] [CrossRef]
- Okamoto, S.; Hijikata-Okunomiya, A.; Wanaka, K.; Okada, Y.; Okamoto, U. Enzyme-Controlling Medicines: Introduction. Semin. Thromb. Hemost. 1997, 23, 493–501. [Google Scholar] [CrossRef] [PubMed]
- Nakajima, J.-I.; Tanaka, I.; Seo, S.; Yamazaki, M.; Saito, K. LC/PDA/ESI-MS Profiling and Radical Scavenging Activity of Anthocyanins in Various Berries. J. Biomed. Biotechnol. 2004, 2004, 241–247. [Google Scholar] [CrossRef] [PubMed]
- Wu, X.; Gu, L.; Prior, R.L.; McKay, S. Characterization of Anthocyanins and Proanthocyanidins in Some Cultivars of Ribes, Aronia, and Sambucu sand Their Antioxidant Capacity. J. Agric. Food Chem. 2004, 52, 7846–7856. [Google Scholar] [CrossRef]
- Jing, P.; Bomser, J.A.; Schwartz, S.J.; He, J.; Magnuson, B.A.; Giusti, M.M. Structure−Function Relationships of Anthocyanins from Various Anthocyanin-Rich Extracts on the Inhibition of Colon Cancer Cell Growth. J. Agric. Food Chem. 2008, 56, 9391–9398. [Google Scholar] [CrossRef]
- Zafra-Stone, S.; Yasmin, T.; Bagchi, M.; Chatterjee, A.; Vinson, J.A.; Bagchi, D. Berry anthocyanins as novel antioxidants in human health and disease prevention. Mol. Nutr. Food Res. 2007, 51, 675–683. [Google Scholar] [CrossRef] [PubMed]
- Zakay-Rones, Z.; Thom, E.; Wollan, T.; Wadstein, J. Randomized Study of the Efficacy and Safety of Oral Elderberry Extract in the Treatment of Influenza A and B Virus Infections. J. Int. Med. Res. 2004, 32, 132–140. [Google Scholar] [CrossRef] [PubMed]
- Bhattacharya, S.; Christensen, K.B.; Olsen, L.C.B.; Christensen, L.P.; Grevsen, K.; Færgeman, N.J.; Kristiansen, K.; Young, J.F.; Oksbjerg, N. Bioactive Components from Flowers of Sambucus nigral. Increase Glucose Uptake in Primary Porcine Myotube Cultures and Reduce Fat Accumulation in Caenorhabditis elegans. J. Agric. Food Chem. 2013, 61, 11033–11040. [Google Scholar] [CrossRef] [PubMed]
- Beaux, D.; Fleurentin, J.; Mortier, F. Effect of extracts of Orthosiphon stamineus benth, Hieracium pilosella l., Sambucus nigra l. and Arctostaphylos uva-ursi l. spreng. in rats. Phytother. Res. 1998, 12, 498–501. [Google Scholar] [CrossRef]
- Chen, L.; Hu, J.Y.; Wang, S.Q. The role of antioxidants in photoprotection: A critical review. J. Am. Acad. Dermatol. 2012, 67, 1013–1024. [Google Scholar] [CrossRef]
- Chrubasik, C.; Maier, T.; Dawid, C.; Torda, T.; Schieber, A.; Hofmann, T.; Chrubasik, S. An observational study and quantification of the actives in a supplement with Sambucus nigra and Asparagus officinalis used for weight reduction. Phytother. Res. 2008, 22, 913–918. [Google Scholar] [CrossRef]
- Folmer, F.; Basavaraju, U.; Jaspars, M.; Hold, G.; El-Omar, E.; Dicato, M.; Han, B.W. Anticancer effects of bioactive berry compounds. Phytochem. Rev. 2013, 13, 295–322. [Google Scholar] [CrossRef]
- Gray, A.M.; Abdel-Wahab, Y.H.A.; Flatt, P.R. The Traditional Plant Treatment, Sambucus nigra (elder), Exhibits Insulin-Like and Insulin-Releasing Actions In Vitro. J. Nutr. 2000, 130, 15–20. [Google Scholar] [CrossRef]
- Picon, P.D.; Picon, R.V.; Costa, A.F.; Sander, G.B.; Amaral, K.M.; Aboy, A.L.; Henriques, A.T. Randomized clinical trial of a phytotherapic compound containing Pimpinella anisum, Foeniculum vulgare, Sambucus nigra, and Cassia augustifolia for chronic constipation. BMC Complement. Altern. Med. 2010, 10, 17. [Google Scholar] [CrossRef]
- Omulokoli, E.; Khan, B.; Chhabra, S. Antiplasmodial activity of four Kenyan medicinal plants. J. Ethnopharmacol. 1997, 56, 133–137. [Google Scholar] [CrossRef]
- Schulz, M.; Chim, J.F. Nutritional and bioactive value of Rubus berries. Food Biosci. 2019, 31, 100438. [Google Scholar] [CrossRef]
- Tiitinen, K.M.; Hakala, A.M.A.; Kallio, H.P. Quality Components of Sea Buckthorn (Hippophaë rhamnoides) Varieties. J. Agric. Food Chem. 2005, 53, 1692–1699. [Google Scholar] [CrossRef] [PubMed]
- Arimboor, R.; Kumar, K.S.; Arumughan, C. Simultaneous estimation of phenolic acids in sea buckthorn (Hippophaë rhamnoides) using RP-HPLC with DAD. J. Pharm. Biomed. Anal. 2008, 47, 31–38. [Google Scholar] [CrossRef] [PubMed]
- Bal, L.M.; Meda, V.; Naik, S.; Satya, S. Sea buckthorn berries: A potential source of valuable nutrients for nutraceuticals and cosmoceuticals. Food Res. Int. 2011, 44, 1718–1727. [Google Scholar] [CrossRef]
- Teleszko, M.; Wojdyło, A.; Rudzińska, M.; Oszmiański, J.; Golis, T. Analysis of Lipophilic and Hydrophilic Bioactive Compounds Content in Sea Buckthorn (Hippophaë rhamnoides L.) Berries. J. Agric. Food Chem. 2015, 63, 4120–4129. [Google Scholar] [CrossRef]
- Guo, R.; Guo, X.; Li, T.; Fu, X.; Liu, R.H. Comparative assessment of phytochemical profiles, antioxidant and antiproliferative activities of Sea buckthorn (Hippophaë rhamnoides L.) berries. Food Chem. 2017, 221, 997–1003. [Google Scholar] [CrossRef]
- Burdulis, D.; Šarkinas, A.; Jasutienė, I.; Stackevicené, E.; Nikolajevas, L.; Janulis, V. Comparative study of anthocyanin composition, antimicrobial and antioxidant activity in bilberry (Vaccinium myrtillus L.) and blueberry (Vaccinium corymbosum L.) fruits. Acta Pol. Pharm. Drug Res. 2009, 66, 399–408. [Google Scholar]
- Bouarab-Chibane, L.; Forquet, V.; Lantéri, P.; Clément, Y.; Léonard-Akkari, L.; Oulahal, N.; Degraeve, P.; Bordes, C. Antibacterial Properties of Polyphenols: Characterization and QSAR (Quantitative Structure–Activity Relationship) Models. Front. Microbiol. 2019, 10, 829. [Google Scholar] [CrossRef]
- Coppo, E.; Marchese, A. Antibacterial activity of polyphenols. Curr. Pharm. Biotechnol. 2014, 15, 380–390. [Google Scholar] [CrossRef]
- Ștefănescu, B.-E.; Călinoiu, L.-F.; Ranga, F.; Fetea, F.; Mocan, A.; Vodnar, D.C.; Crișan, G. Chemical Composition and Biological Activities of the Nord-West Romanian Wild Bilberry (Vaccinium myrtillus L.) and Lingonberry (Vaccinium vitis-idaea L.) Leaves. Antioxidants 2020, 9, 495. [Google Scholar] [CrossRef]
- Piqueras-Fiszman, B.; Jaeger, S.R. The impact of the means of context evocation on consumers’ emotion associations towards eating occasions. Food Qual. Prefer. 2014, 37, 61–70. [Google Scholar] [CrossRef]
- Piqueras-Fiszman, B.; Jaeger, S.R. Emotion responses under evoked consumption contexts: A focus on the consumers’ frequency of product consumption and the stability of responses. Food Qual. Prefer. 2014, 35, 24–31. [Google Scholar] [CrossRef]
- Shim, H.-K.; Lee, C.L.; Valentin, D.; Hong, J.-H. How a combination of two contradicting concepts is represented: The representation of premium instant noodles and premium yogurts by different age groups. Food Res. Int. 2019, 125, 108506. [Google Scholar] [CrossRef]
- Cardello, A.V.; Meiselman, H.L.; Schutz, H.G.; Craig, C.; Given, Z.; Lesher, L.L.; Eicher, S. Measuring emotional responses to foods and food names using questionnaires. Food Qual. Prefer. 2012, 24, 243–250. [Google Scholar] [CrossRef]
- Dalenberg, J.R.; Gutjar, S.; Ter Horst, G.J.; De Graaf, K.; Renken, R.J.; Jager, G. Evoked Emotions Predict Food Choice. PLoS ONE 2014, 9, e115388. [Google Scholar] [CrossRef]
- Spinelli, S.; Monteleone, E. Emotional Responses to Products. In Technology and Nutrition, Methods in Consumer Research; Woodhead Publishing: Sawston/Cambridge, UK, 2018; pp. 261–296. ISBN 978-0-08-102089-0. [Google Scholar]
- Smith, D.C.; Aaker, D.A. Managing Brand Equity: Capitalizing on the Value of a Brand Name. J. Mark. 1992, 56, 125–128. [Google Scholar] [CrossRef]
- Meiselman, H.L. A review of the current state of emotion research in product development. Food Res. Int. 2015, 76, 192–199. [Google Scholar] [CrossRef]
- Spinelli, S.; Masi, C.G.; Zoboli, G.P.; Prescott, J.M.; Monteleone, E. Emotional responses to branded and unbranded foods. Food Qual. Prefer. 2015, 42, 1–11. [Google Scholar] [CrossRef]
- Moskowitz, H.R. Sensory Drivers of Liking and Sensory Preference Segmentation. In Proceedings of the ACS Symposium Series, American Chemical Society (ACS). Chem. Taste 2002, 825, 214–226. [Google Scholar] [CrossRef]
- Guinard, J.-X. Internal and External Preference Mapping: Understanding Market Segmentation and Identifying Drivers of Liking. In Proceedings of the ACS Symposium Series, American Chemical Society (ACS). Chem. Taste 2002, 825, 227–242. [Google Scholar] [CrossRef]
- King, S.C. Emotions Elicited by Foods. In Emotion Measurement; Woodhead Publishing: Sawston/Cambridge, UK, 2016; pp. 455–472. ISBN 9780081005088. [Google Scholar]
- Van Zyl, H. Emotion in Beverages. Emotion Measurement; Woodhead Publishing: Sawston/Cambridge, UK, 2016; pp. 473–499. ISBN 978-0-08-1005088. [Google Scholar]
- Thomson, D.M.; Crocker, C.; Marketo, C.G. Linking sensory characteristics to emotions: An example using dark chocolate. Food Qual. Prefer. 2010, 21, 1117–1125. [Google Scholar] [CrossRef]
- Spinelli, S.; Masi, C.; Dinnella, C.; Zoboli, G.P.; Monteleone, E. How does it make you feel? A new approach to measuring emotions in food product experience. Food Qual. Prefer. 2014, 37, 109–122. [Google Scholar] [CrossRef]
- Gutjar, S.; Dalenberg, J.R.; De Graaf, C.; De Wijk, R.A.; Palascha, A.; Renken, R.J.; Jager, G. What reported food-evoked emotions may add: A model to predict consumer food choice. Food Qual. Prefer. 2015, 45, 140–148. [Google Scholar] [CrossRef]
- Mora, M.; Urdaneta, E.; Chaya, C. Emotional response to wine: Sensory properties, age and gender as drivers of consumers’ preferences. Food Qual. Prefer. 2018, 66, 19–28. [Google Scholar] [CrossRef]
- Jaeger, S.R.; Xia, Y.; Le Blond, M.; Beresford, M.K.; Hedderley, D.I.; Cardello, A.V. Supplementing hedonic and sensory consumer research on beer with cognitive and emotional measures, and additional insights via consumer segmentation. Food Qual. Prefer. 2019, 73, 117–134. [Google Scholar] [CrossRef]
- Mora, M.; Giussani, B.; Pagliarini, E.; Chaya, C. Improvement of an emotional lexicon for the evaluation of beers. Food Qual. Prefer. 2019, 71, 158–162. [Google Scholar] [CrossRef]
- Gálvez, A.; López, R.L.; Pulido, R.P.; Burgos, M.J.G. Listeria Monocytogenes in the Food Processing Environment; SpringerBriefs in Food, Health, and Nutrition; Springer: Cham, Switzerland, 2014; pp. 3–14. [Google Scholar] [CrossRef]
- Cizeikiene, D.; Juodeikiene, G.; Paskevicius, A.; Bartkiene, E. Antimicrobial activity of lactic acid bacteria against pathogenic and spoilage microorganism isolated from food and their control in wheat bread. Food Control. 2013, 31, 539–545. [Google Scholar] [CrossRef]
- Bartkiene, E.; Lele, V.; Sakiene, V.; Zavistanaviciute, P.; Ruzauskas, M.; Bernatoniene, J.; Jakstas, V.; Viskelis, P.; Zadeike, D.; Juodeikiene, G. Improvement of the antimicrobial activity of lactic acid bacteria in combination with berries/fruits and dairy industry by-products. J. Sci. Food Agric. 2019, 99, 3992–4002. [Google Scholar] [CrossRef]
- Bartkiene, E.; Krungleviciute, V.; Antanaitis, R.; Kantautaite, J.; Ruzauskas, M.; Vaskeviciute, L.; Siugzdiniene, R.; Kucinskiene, J.; Juodeikiene, G.; Kucinskas, A.; et al. Antimicrobial activity of lactic acid bacteria multiplied in an alternative substrate and their influence on physiological parameters of new-born calves. Veterinární Med. 2016, 61, 653–662. [Google Scholar] [CrossRef]
- Barbosa, A.A.T.; Mantovani, H.C.; Jain, S. Bacteriocins from lactic acid bacteria and their potential in the preservation of fruit products. Crit. Rev. Biotechnol. 2017, 37, 852–864. [Google Scholar] [CrossRef]
- Elsanhoty, R.; Ghonamy, A.; El-Adly, N.; Ramadan, M.F. Impact of Lactic Acid Bacteria and Bifidobacterium on the Survival of Bacillus subtilus During Fermentation of Wheat Sourdough. J. Food Process. Preserv. 2016, 41, e13086. [Google Scholar] [CrossRef]
- Rumjuankiat, K.; Keawsompong, S.; Nitisinprasert, S. Bacterial contaminants from frozen puff pastry production process and their growth inhibition by antimicrobial substances from lactic acid bacteria. Food Sci. Nutr. 2016, 5, 454–465. [Google Scholar] [CrossRef] [PubMed]
- Hernandez, B.; Sáenz, C.; Alberdi, C.; Diñeiro, J.M. CIELAB color coordinates versus relative proportions of myoglobin redox forms in the description of fresh meat appearance. J. Food Sci. Technol. 2016, 53, 4159–4167. [Google Scholar] [CrossRef]
- Palacios-Morillo, A.; Jurado, J.M.; Alcázar, A.; Pablos, F. Differentiation of Spanish paprika from Protected Designation of Origin based on color measurements and pattern recognition. Food Control. 2016, 62, 243–249. [Google Scholar] [CrossRef]
- Ștefănescu, B.-E.; Călinoiu, L.F.; Ranga, F.; Fetea, F.; Mocan, A.; Vodnar, D.C.; Crisan, G. The Chemical and Biological Profiles of Leaves from Commercial Blueberry Varieties. Plants 2020, 9, 1193. [Google Scholar] [CrossRef]
- Amaretti, A.; Di Nunzio, M.; Pompei, A.; Raimondi, S.; Rossi, M.; Bordoni, A. Antioxidant properties of potentially probiotic bacteria: In vitro and in vivo activities. Appl. Microbiol. Biotechnol. 2012, 97, 809–817. [Google Scholar] [CrossRef]
- Goud, N.S.; Prasad, G. Antioxidant, Antimicrobial Activity and Total Phenol and Flavonoids Analysis of Sambucus Nigra (Elderberry). Int. J. Curr. Pharm. Res. 2020, 12, 35–37. [Google Scholar] [CrossRef]
- Rice-Evans, C.; Miller, N.; Paganga, G. Antioxidant properties of phenolic compounds. Trends Plant Sci. 1997, 2, 152–159. [Google Scholar] [CrossRef]
- Zadernowski, R.; Naczk, M.; Nesterowicz, J. Phenolic Acid Profiles in Some Small Berries. J. Agric. Food Chem. 2005, 53, 2118–2124. [Google Scholar] [CrossRef]
- Yang, J.W.; Choi, I.S. Comparison of the phenolic composition and antioxidant activity of Korean black raspberry, Bokbunja, (Rubus coreanus Miquel) with those of six other berries. CyTA J. Food 2016, 15, 1–8. [Google Scholar] [CrossRef]
- Hidalgo, G.-I.; Almajano, M.P. Red Fruits: Extraction of Antioxidants, Phenolic Content, and Radical Scavenging Determination: A Review. Antioxidants 2017, 6, 7. [Google Scholar] [CrossRef]
- Lee, J.; Dossett, M.; Finn, C.E. Rubus fruit phenolic research: The good, the bad, and the confusing. Food Chem. 2012, 130, 785–796. [Google Scholar] [CrossRef]
- Lazar, T.; Taiz, L.; Zeiger, E. Plant physiology. Ann. Bot. 2003, 91, 750–751. [Google Scholar] [CrossRef]
- Gao, X.; Ohlander, M.; Jeppsson, N.; Björk, L.; Trajkovski, V. Changes in Antioxidant Effects and Their Relationship to Phytonutrients in Fruits of Sea Buckthorn (Hippophae rhamnoides L.) during Maturation. J. Agric. Food Chem. 2000, 48, 1485–1490. [Google Scholar] [CrossRef]
- Kim, J.-S.; Kwon, Y.-S.; Sa, Y.-J.; Kim, M.-J. Isolation and Identification of Sea Buckthorn (Hippophae rhamnoides) Phenolics with Antioxidant Activity and α-Glucosidase Inhibitory Effect. J. Agric. Food Chem. 2011, 59, 138–144. [Google Scholar] [CrossRef]
- Rösch, D.; Bergmann, M.; Knorr, A.D.; Kroh, L.W. Structure−Antioxidant Efficiency Relationships of Phenolic Compounds and Their Contribution to the Antioxidant Activity of Sea Buckthorn Juice. J. Agric. Food Chem. 2003, 51, 4233–4239. [Google Scholar] [CrossRef]
- Domazetovic, V.; Marcucci, G.; Falsetti, I.; Bilia, A.R.; Vincenzini, M.T.; Brandi, M.L.; Iantomasi, T. Blueberry Juice Antioxidants Protect Osteogenic Activity against Oxidative Stress and Improve Long-Term Activation of the Mineralization Process in Human Osteoblast-Like SaOS-2 Cells: Involvement of SIRT1. Antioxidants 2020, 9, 125. [Google Scholar] [CrossRef]
Publisher’s Note: MDPI stays neutral with regard to jurisdictional claims in published maps and institutional affiliations. |
© 2020 by the authors. Licensee MDPI, Basel, Switzerland. This article is an open access article distributed under the terms and conditions of the Creative Commons Attribution (CC BY) license (http://creativecommons.org/licenses/by/4.0/).